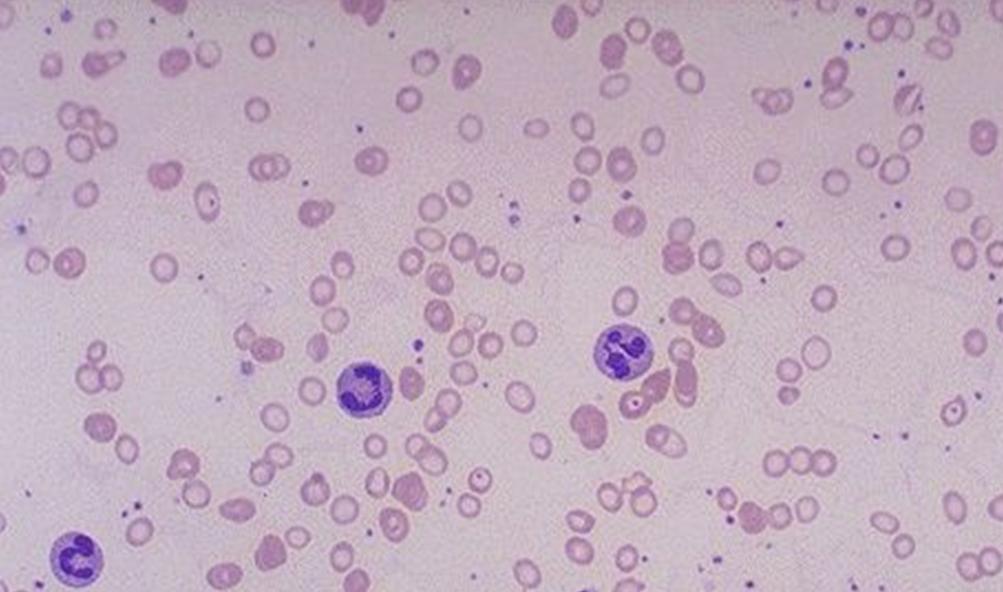
在寄生人体消化道的线虫中,钩虫的危害性最严重,由于钩虫的 a href="

钩虫口囊

十二指肠钩虫口囊 美洲钩虫口囊
图片尺寸1080x810
在寄生人体消化道的线虫中,钩虫的危害性最严重,由于钩虫的 a href="
图片尺寸1000x862
在寄生人体消化道的线虫中,钩虫的危害性最严重,由于钩虫的 a href="
图片尺寸592x376
p>十二指肠钩口线虫(ancylostoma duodenale),简称为十二指肠钩虫,寄
图片尺寸1275x966
在寄生人体消化道的线虫中,钩虫的危害性最严重,由于钩虫的 a href="
图片尺寸460x378
钩虫
图片尺寸1030x862
蠕虫病
图片尺寸600x810
带您认识钩虫
图片尺寸365x572
两种钩虫口囊扫描电镜图
图片尺寸498x214
按照你所说的描述,应该是土壤中的钩虫 体长约1厘米左右,半透明,灰白
图片尺寸510x783
钩虫201201ppt
图片尺寸800x600
在寄生人体消化道的线虫中,钩虫的危害性最严重,由于钩虫的 a href="
图片尺寸746x414
钩虫生活史线条图a.寄生部位:小肠;b.排卵途径:随粪便;c.
图片尺寸1080x792
十二指肠钩口线虫成虫 (十二指肠钩虫成虫) 美洲板口线虫成虫 (美洲
图片尺寸1080x810
p>十二指肠钩口线虫(ancylostoma duodenale),简称为十二指肠钩虫,寄
图片尺寸800x741
昨日「虫」现-在检验科养钩虫是一种什么样的体验?
图片尺寸413x359
p>十二指肠钩口线虫(ancylostoma duodenale),简称为十二指肠钩虫,寄
图片尺寸592x390
卵班氏微丝蚴旋毛虫囊包示教标本:钩虫口囊蛔虫唇瓣鞭虫卵蛲虫卵蛔虫
图片尺寸1024x768
在寄生人体消化道的线虫中,钩虫的危害性最严重,由于钩虫的 a href="
图片尺寸1003x592
钩虫的简笔画
图片尺寸380x536

























.jpg)